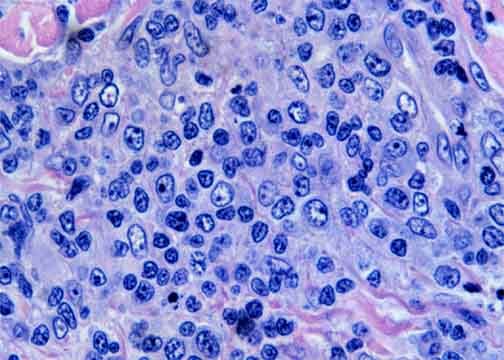

Go to:

TOC
|
Peripheral T-Cell Lymphomas: Example 3A
This patient's lymphoma progressed to a more aggressive form.

This is another example of a PTCL in the skin. Compare the degree
of involvement (and the cellular composition as seen below) with another
skin PTCL. Note the epidermal sparing.
Fairly dense lymphoid aggregates are centered in the deep dermis
around vessels and appendages. This pattern is shared by most B-cell lymphomas
and cutaneous T-cell lymphomas that are not mycosis fungoides.
|
A mixture of small and large atypical cells.
|
Table of Contents
|